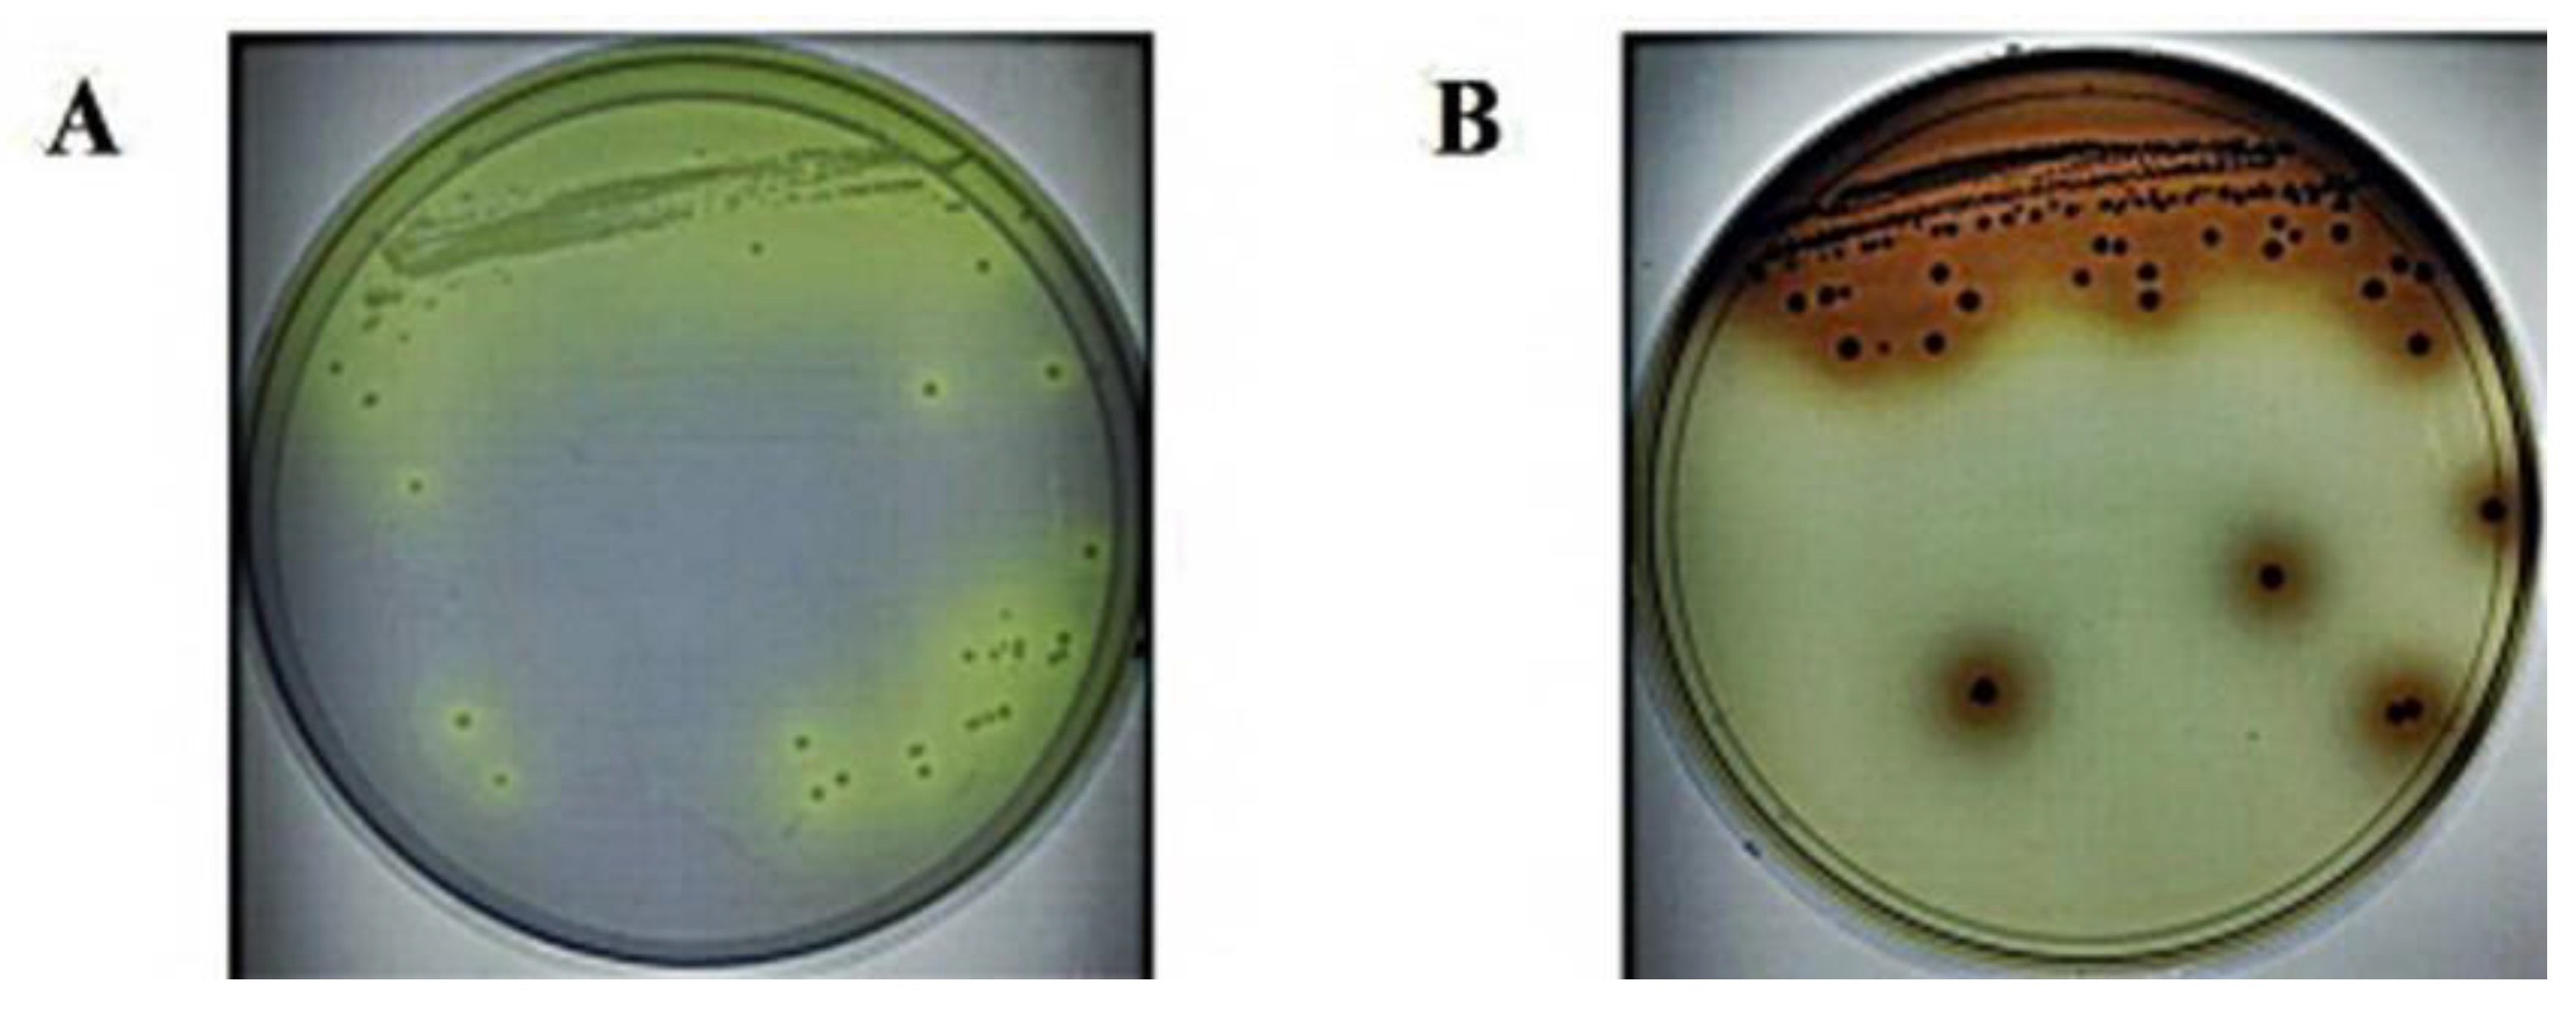
Foods 11 00529 g001

Identification of β-Glucosidase Activity of Lentilactobacillus buchneri URN103L and Its Potential to Convert Ginsenoside Rb1 from Panax ginseng
Abstract
:1. Introduction
2. Materials and Methods
2.1. Isolation of LAB with β-Glucosidase Activity from Fermented Plants
2.2. 16S rDNA Sequencing of Strain URN103L
2.3. Identification of Enzyme Activity of the Strain URN103L Using the API ZYM Kit
2.4. Determination of Optimum pH for β-Glucosidase Hydrolysis of Ginsenoside Rb1
2.5. Determination of Optimum Temperature for β-Glucosidase Hydrolysis of Ginsenoside Rb1
2.6. Thin-Layer Chromatography and High-Performance Liquid Chromatography (HPLC)
2.7. Hydrolysis of Ginsenoside Rb1 by L. buchneri URN103L under Optimum Conditions
2.8. Fermentation Characteristics of a 20% Ginseng Root Solution Fermented by L. buchneri URN103L
2.9. Statistics Analysis
3. Results and Discussion
3.1. Isolation and Screening of LAB with β-Glucosidase Activity from Fermented Plants
3.2. Selection of Colonies That Can Hydrolyze Ginsenosides
3.3. β-Glucosidase Activity of the Selected Strain URN103L
3.4. 16S rDNA Sequencing of Strain URN103L
3.5. Optimum pH and Temperature of β-Glucosidase and Conversion of Ginsenoside Rb1
3.6. Metabolism of Ginsenoside Rb1 by β-Glucosidase Extracted from L. buchneri URN103L
3.7. Characteristics of the Fermentation of 20% Ginseng Root Solution by L. buchneri URN103L
4. Conclusions
Author Contributions
Funding
Institutional Review Boarding Statement
Informed Consent Statement
Data Availability Statement
Acknowledgments
Conflicts of Interest
References
- Kim, M.W.; Ko, S.R.; Choi, K.J.; Kim, S.C. Distribution of saponin in various sections of Panax ginseng root and changes of its content according to root age. J. Ginseng Res. 1987, 11, 10–16. [Google Scholar]
- Park, S.E.; Na, C.S.; Yoo, S.A.; Seo, S.H.; Son, H.S. Biotransformation of major ginsenosides in ginsenoside model culture by lactic acid bacteria. J. Ginseng Res. 2017, 41, 36–42. [Google Scholar] [CrossRef] [PubMed] [Green Version]
- Jia, L.; Zhao, Y.; Liang, X.J. Current evaluation of the millennium phytomedicine- ginseng (II): Collected chemical entities, modern pharmacology, and clinical applications emanated from traditional Chinese medicine. Curr. Med. Chem. 2009, 16, 2924–2942. [Google Scholar] [CrossRef] [PubMed]
- Park, J.S.; Shin, J.A.; Jung, J.S.; Hyun, J.W.; Van Le, T.K.; Kim, D.H.; Park, E.M.; Kim, H.S. Anti-inflammatory mechanism of compound K in activated microglia and its neuroprotective effect on experimental stroke in mice. J. Pharmacol. Exp. Ther. 2012, 341, 59–67. [Google Scholar] [CrossRef]
- Radad, K.; Moldzio, R.; Rausch, W.D. Ginsenosides and their CNS targets. CNS. Neurosci. Ther. 2011, 17, 761–768. [Google Scholar] [CrossRef]
- Michlmayr, H.; Kneifel, W. beta-Glucosidase activities of lactic acid bacteria: Mechanisms, impact on fermented food and human health. FEMS. Microbiol. Lett. 2014, 352, 1–10. [Google Scholar] [CrossRef] [Green Version]
- Chi, H.; Ji, G.E. Transformation of ginsenosides Rb1 and Re from Panax ginseng by food microorganisms. Biotechnol. Lett. 2005, 27, 765–771. [Google Scholar] [CrossRef]
- Lin, T.; Liu, Y.; Shi, M.; Liu, X.; Li, L.; Liu, Y.; Zhao, G. Promotive effect of ginsenoside Rd on proliferation of neural stem cells in vivo and in vitro. J. Ethnopharmacol. 2012, 142, 754–761. [Google Scholar] [CrossRef]
- Kim, B.J. Involvement of melastatin type transient receptor potential 7 channels in ginsenoside Rd-induced apoptosis in gastric and breast cancer cells. J. Ginseng Res. 2013, 37, 201–209. [Google Scholar] [CrossRef] [Green Version]
- Chen, X.J.; Zhang, X.J.; Shui, Y.M.; Wan, J.B.; Gao, J.L. Anticancer Activities of Protopanaxadiol- and Protopanaxatriol-Type Ginsenosides and Their Metabolites. Evid. Based. Complement. Alternat. Med. 2016, 2016, 5738694. [Google Scholar] [CrossRef] [Green Version]
- Kleinschmit, D.H.; Schmidt, R.J.; Kung, L., Jr. The effects of various antifungal additives on the fermentation and aerobic stability of corn silage. J. Dairy Sci. 2005, 88, 2130–2139. [Google Scholar] [CrossRef] [Green Version]
- Mahdi, L.; Mathkhury, H.J.F.; Kakei, S.; Habeeb, K.; Zwain, L.; Muhammed Ali Salman, I.; Mahdi, N.Z.; Kaabi, S.; Nazar, N. Antibacterial activity of lactobacillus buchneri bacteriocin against vibrio parahaemolyticus. Curr. Appl. Sci. Technol. 2017, 17, 81–86. [Google Scholar]
- Renchinkhand, G.; Cho, S.H.; Urgamal, M.; Park, Y.W.; Nam, J.H.; Bae, H.C.; Song, G.Y.; Nam, M.S. Characterization of Paenibacillus sp. MBT213 Isolated from Raw Milk and Its Ability to Convert Ginsenoside Rb1 into Ginsenoside Rd from Panax ginseng. Korean. J. Food Sci. Anim. Resour. 2017, 37, 735–742. [Google Scholar] [CrossRef] [PubMed] [Green Version]
- Renchinkhand, G.; Cho, S.H.; Park, Y.W.; Song, G.Y.; Nam, M.S. Biotransformation of Major Ginsenoside Rb1 to Rd by Dekkera anomala YAE-1 from Mongolian Fermented Milk (Airag). J. Microbiol. Biotechnol. 2020, 30, 1536–1542. [Google Scholar] [CrossRef] [PubMed]
- Renchinkhand, G.; Park, Y.W.; Song, G.-Y.; Cho, S.-H.; Urgamal, M.; Bae, H.C.; Choi, J.W.; Nam, M.S. Identification of β-Glucosidase Activity of Enterococcus Faecalis CRNB-A3 in Airag and Its Potential to Convert Ginsenoside Rb1 from Panax Ginseng. J. Food Biochem. 2016, 40, 120–129. [Google Scholar] [CrossRef]
- Cho, Y.R.; Chang, J.Y.; Chang, H.C. Production of gamma-aminobutyric acid (GABA) by Lactobacillus buchneri isolated from kimchi and its neuroprotective effect on neuronal cells. J. Microbiol. Biotechnol. 2007, 17, 104–109. [Google Scholar]
- Cheon, M.J.; Lim, S.M.; Lee, N.K.; Paik, H.D. Probiotic Properties and Neuroprotective Effects of Lactobacillus buchneri KU200793 Isolated from Korean Fermented Foods. Int. J. Mol. Sci. 2020, 21, 1227. [Google Scholar] [CrossRef] [Green Version]
- Zeng, X.Q.; Pan, D.D.; Guo, Y.X. The probiotic properties of Lactobacillus buchneri P2. J. Appl. Microbiol. 2010, 108, 2059–2066. [Google Scholar] [CrossRef]
- Humble, M.W.; King, A.; Phillips, I. API ZYM: A simple rapid system for the detection of bacterial enzymes. J. Clin. Pathol. 1977, 30, 275–277. [Google Scholar] [CrossRef] [Green Version]
- Pérez, G.; Fariña, L.; Barquet, M.; Boido, E.; Gaggero, C.; Dellacassa, E.; Carrau, F. A quick screening method to identify β-glucosidase activity in native wine yeast strains: Application of Esculin Glycerol Agar (EGA) medium. World J. Microbiol. Biotechnol. 2011, 27, 47–55. [Google Scholar] [CrossRef]
- Matsuda, S.; Norimoto, F.; Matsumoto, Y.; Ohba, R.; Teramoto, Y.; Ohta, N.; Ueda, S. Solubilization of a novel isoflavone glycoside-hydrolyzing β-glucosidase from Lactobacillus casei subsp. rhamnosus. J. Ferment. Bioeng. 1994, 77, 439–441. [Google Scholar] [CrossRef]
- Gueguen, Y.; Chemardin, P.; Labrot, P.; Arnaud, A.; Galzy, P. Purification and characterization of an intracellular beta-glucosidase from a new strain of Leuconostoc mesenteroides isolated from cassava. J. Appl. Microbiol. 1997, 82, 469–476. [Google Scholar] [CrossRef] [Green Version]
- Sestelo, A.B.F.; Poza, M.; Villa, T.G. β-Glucosidase Activity in a Lactobacillus Plantarum Wine Strain. World. J. Microbiol. Biotechnol. 2004, 20, 633. [Google Scholar] [CrossRef]
- Kok, F.S.; Muhamad, I.I.; Lee, C.T.; Razali, F.; Pa’e, N.; Shaharuddin, S. Effects of pH and Temperature on the Growth and β-Glucosidase Activity of Lactobacillus Rhamnosus NRRL 442 in Anaerobic Fermentation. Int. Rev. Chem. Eng. 2012, 4, 293–299. [Google Scholar]
- Kim, S.H.; Min, J.W.; Quan, L.H.; Lee, S.; Yang, D.U.; Yang, D.C. Enzymatic Transformation of Ginsenoside Rb1 by Lactobacillus pentosus Strain 6105 from Kimchi. J. Ginseng Res. 2012, 36, 291–297. [Google Scholar] [CrossRef] [PubMed] [Green Version]
- Ko, S.R.; Suzuki, Y.; Suzuki, K.; Choi, K.J.; Cho, B.G. Marked production of ginsenosides Rd, F2, Rg3, and compound K by enzymatic method. Chem. Pharm. Bull. 2007, 55, 1522–1527. [Google Scholar] [CrossRef] [Green Version]
- Quan, L.H.; Piao, J.Y.; Min, J.W.; Yang, D.U.; Lee, H.N.; Yang, D.C. Bioconversion of ginsenoside Rb1 into compound k by Leuconostoc citreum LH1 isolated from kimchi. Braz. J. Microbiol. 2011, 42, 1227–1237. [Google Scholar] [CrossRef]
- Park, B.; Hwang, H.; Lee, J.; Sohn, S.-O.; Lee, S.H.; Jung, M.Y.; Lim, H.I.; Park, H.W.; Lee, J.-H. Evaluation of ginsenoside bioconversion of lactic acid bacteria isolated from kimchi. J. Ginseng Res. 2017, 41, 524–530. [Google Scholar] [CrossRef] [Green Version]
- Identification of β-Glucosidase Activity of Lactobacillus plantarum CRNB22 in Kimchi and Its Potential to Con vert Ginsenoside Rb1 from Panax Ginseng. J. Food Chem. 2015, 39, 155–163. [CrossRef]
- Luo, X.; Wang, C.-Z.; Chen, J.; Song, W.-X.; Luo, J.; Tang, N.; He, B.-C.; Kang, Q.; Wang, Y.; Du, W.; et al. Characterization of gene expression regulated by American ginseng and ginsenoside Rg3 in human colorectal cancer cells. Inter. J. Oncol. 2008, 32, 975–983. [Google Scholar] [CrossRef] [Green Version]
- Wang, L.; Li, X.; Song, Y.-M.; Wang, B.; Zhang, F.-R.; Yang, R.; Wang, H.-Q.; Zhang, G.-J. Ginsenoside Rg3 sensitizes human non-small cell lung cancer cells to γ-radiation by targeting the nuclear factor-κB pathway. Mol Med Rep 2015, 27, 609–614. [Google Scholar] [CrossRef] [PubMed] [Green Version]
- Kim, B.M.; Kim, D.H.; Park, J.H.; Na, H.K.; Surh, Y.J. GinsenosideRg3 induces apoptosis of human breast cancer (MDA-MB-231) cells. J. Cancer Prev. 2013, 18, 177–185. [Google Scholar] [CrossRef] [PubMed] [Green Version]
- Kim, B.M.; Kim, D.H.; Park, J.H.; Surh, Y.J.; Na, H.K. GinsenosideRg3 inhibits constitutive activation of NF-κB signaling in human breast cancer (MDA-MB-231) cells: ERK and Akt as potential upstream targets. J. Cancer Prev. 2014, 19, 23–30. [Google Scholar] [CrossRef]
- Yuan, H.D.; Quan, H.Y.; Zhang, Y.; Kim, S.H.; Chung, S.H. 20(S)-ginsenoside Rg3-induced apoptosis in HT-29 colon cancer cells is associated with AMPK signaling pathway. Mol. Med. Rep. 2010, 3, 825–831. [Google Scholar] [PubMed] [Green Version]
- Junmin, S.; Hongxiang, L.; Zhen, L.; Chao, Y.; Chaojie, W. Ginsenoside Rg3 inhibits colon cancer cell migration by suppressing nuclear factor kappa B activity. J. Tradit Chin. Med. 2015, 35, 440–444. [Google Scholar] [CrossRef]
- Aziz, F.; Wang, X.; Liu, J.; Yan, Q. Ginsenoside Rg3 induces FUT4-mediated apoptosis in H. pylori CagA-treated gastric cancer cells by regulating SP1 and HSF1 expressions. Toxicol. In Vitro 2016, 31, 158–166. [Google Scholar] [CrossRef]
- Joo, E.J.; Chun, J.; Ha, Y.W.; Ko, H.J.; Xu, M.Y.; Kim, Y.S. Novel roles of ginsenoside Rg3 in apoptosis through downregulation of epidermal growth factor receptor. Chem. Biol. Interact. 2015, 233, 25–34. [Google Scholar] [CrossRef]
- Jiang, J.W.; Chen, X.M.; Chen, X.H.; Zheng, S.S. Ginsenoside Rg3 inhibit hepatocellular carcinoma growth via intrinsic apoptotic pathway. World J. Gastroenterol. 2011, 17, 3605–3613. [Google Scholar] [CrossRef]
- Sun, M.; Ye, Y.; Xiao, L.; Duan, X.; Zhang, Y.; Zhang, H. Anticancer effects of ginsenoside Rg3 (Review). Int. J. Mol. Med. 2017, 39, 507–518. [Google Scholar] [CrossRef] [Green Version]
- Yang, N.; Liang, G.; Lin, J.; Zhang, S.; Lin, Q.; Ji, X.; Chen, H.; Li, N.; Jin, S. Ginsenoside Rd therapy improves histological and functional recovery in a rat model of inflammatory bowel disease. Phytother. Res. 2020, 34, 3019–3028. [Google Scholar] [CrossRef]

| Microorganism (Log CFU mL−1) | Incubation Time (Days) | |||
|---|---|---|---|---|
| 0 | 3 | 7 | 14 | |
| Lentilactobacillus buchneri URN103L | 6.04 ± 0.08 d | 7.88 ± 0.09 b | 8.27 ± 0.04 a | 7.39 ± 0.08 c |
Publisher’s Note: MDPI stays neutral with regard to jurisdictional claims in published maps and institutional affiliations. |
© 2022 by the authors. Licensee MDPI, Basel, Switzerland. This article is an open access article distributed under the terms and conditions of the Creative Commons Attribution (CC BY) license (https://creativecommons.org/licenses/by/4.0/).
Share and Cite
Renchinkhand, G.; Magsar, U.; Bae, H.C.; Choi, S.-H.; Nam, M.S. Identification of β-Glucosidase Activity of Lentilactobacillus buchneri URN103L and Its Potential to Convert Ginsenoside Rb1 from Panax ginseng. Foods 2022, 11, 529. https://doi.org/10.3390/foods11040529
Renchinkhand G, Magsar U, Bae HC, Choi S-H, Nam MS. Identification of β-Glucosidase Activity of Lentilactobacillus buchneri URN103L and Its Potential to Convert Ginsenoside Rb1 from Panax ginseng. Foods. 2022; 11(4):529. https://doi.org/10.3390/foods11040529
Chicago/Turabian StyleRenchinkhand, Gereltuya, Urgamal Magsar, Hyoung Churl Bae, Suk-Ho Choi, and Myoung Soo Nam. 2022. "Identification of β-Glucosidase Activity of Lentilactobacillus buchneri URN103L and Its Potential to Convert Ginsenoside Rb1 from Panax ginseng" Foods 11, no. 4: 529. https://doi.org/10.3390/foods11040529
APA StyleRenchinkhand, G., Magsar, U., Bae, H. C., Choi, S.-H., & Nam, M. S. (2022). Identification of β-Glucosidase Activity of Lentilactobacillus buchneri URN103L and Its Potential to Convert Ginsenoside Rb1 from Panax ginseng. Foods, 11(4), 529. https://doi.org/10.3390/foods11040529







